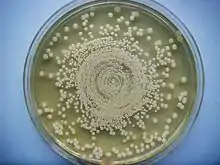

Jane Hinton
Jane Hinton (1919–2003) was a pioneer in the study of bacterial antibiotic resistance and one of the first two African-American women to gain the degree of Doctor of Veterinary Medicine (1949).[1] Prior to her veterinary medicine studies at the University of Pennsylvania, she had been a laboratory technician at Harvard, co-developing the Mueller–Hinton agar, a culture medium that is now commonly used to test bacterial susceptibility to antibiotics.[2][3] She later practiced as a small animal veterinarian in Massachusetts, and then as a federal government inspector.[1] Hinton was the daughter of William Augustus Hinton, a microbiologist and the first African-American professor at Harvard University.
Jane Hinton | |
|---|---|
 | |
| Born | May 1, 1919 |
| Died | April 9, 2003 (aged 83) |
| Alma mater | |
| Known for |
|
Early life and education
Jane Hinton was born on May 1, 1919.[4] Her father, William Augustus Hinton (1883–1959), was a bacteriologist and pathologist who was an expert in the diagnosis and treatment of syphilis, including the development of tests for syphilis.[5] The son of former slaves,[6] he was the first African-American professor at Harvard University and the first African-American author of a textbook. He entered laboratory medicine because racism in Boston prevented him from gaining an internship in medicine.[7] Jane Hinton's mother was Ada Hawes (b. 1878), a high school teacher and social worker, born in Georgia.[8][9][10] William and Ada married in 1909,[7] and had two daughters, Jane and Ann Hinton Jones.[4][11] Jane Hinton earned her undergraduate degree at the age of 20 from Simmons College in 1939.[12]
Career
In 1931, Hinton's father developed a Medical Laboratory Techniques course, which was open to women, although that profession was then generally not open to women.[13] Jane Hinton worked in Harvard's laboratories at the time she co-developed the Mueller–Hinton agar with John Howard Mueller.[3] This agar was a medium developed to isolate the Neisseria bacteria that caused gonorrhea and meningogoccal meningitis.[14] Mueller and Hinton discovered that starch within the agar helped aid bacterial growth and prevented bacteria toxins from interfering with antibiotic testing.[14] It became the most widely used culture medium for Neisseria. In the 1960s, tests indicated its suitability for detecting whether bacteria are susceptible to antibiotics.[2] The Clinical and Laboratory Standards Institute, which establishes the best international laboratory standards, adopted the Kirby–Bauer technique using Mueller–Hinton agar as the gold standard for antibiotic testing.[14]
During World War II, Hinton also worked as a lab technician in Arizona.[15] After the War, Hinton studied veterinary medicine at the University of Pennsylvania, gaining her Doctor of Veterinary Medicine (VMD) degree in 1949. She and Alfreda Johnson Webb, who graduated with a VMD from the Tuskegee Institute (now Tuskegee University) that year, were the first African-American women veterinarians.[1] There had been only four African-American VMD graduates at the University of Pennsylvania before Hinton gained her degree, and there would not be another until 1968.[16] Hinton and Webb were also the first African-American members of the Women's Veterinary Medicine Association.[17]
After gaining her degree, Hinton practiced as a small animal veterinarian in Canton, Massachusetts, and then a federal government inspector in Framingham, Massachusetts.[1]
Jane Hinton, together with John Taylor, the first African-American graduate of the University of Pennsylvania veterinary medicine school, were honored during the school's centennial celebrations by the Minority Veterinary Students association in 1984.[18]
Jane Hinton died on April 9, 2003.[19]
References
- Smith, Jessie Carney (2013). Handy African American history answer book. ISBN 978-1578594887. Retrieved February 26, 2017.
- "Product Information and Quality Control Sheet: Mueller Hinton Agar" (PDF). Health Link. Retrieved February 26, 2017.
- Mueller, J. H.; Hinton, J. (October 1, 1941). "A Protein-Free Medium for Primary Isolation of the Gonococcus and Meningococcus". Experimental Biology and Medicine. 48 (1): 330–333. doi:10.3181/00379727-48-13311.
- Harvard College (1920). Harvard College Class of 1905 Fourth Report. Plimpton Press. p. 155.
- "William Augustus Hinton, M.D., Ph.D." ASM.org. Retrieved June 10, 2020.
- Decker, Ed. "William Augustus Hinton 1883–1959". Encyclopedia.com. Retrieved February 26, 2017.
- Gates Jr., Henry Louis; Higginbotham, Evelyn Brooks, eds. (2004). African American Lives. Oxford University Press. ISBN 978-0199882861.
- Who's who in Massachusetts. Larkin, Roosevelt & Larkin. 1940. p. 384. Retrieved February 26, 2017.
- Adams, Myron Winslow (1918). General Catalogue of Atlanta University, Atlanta, Georgia: 1867-1918. Atlanta University Press. p. 45. Retrieved February 26, 2017.
- Tucker, Cynthia Grant (2010). No silent witness the Eliot parsonage women and their Unitarian world. Oxford: Oxford University Press. p. 191. ISBN 978-0199780143. Retrieved February 26, 2017.
- "Dr. William A. Hinton dies; led fight against syphilis". St. Louis Post-Dispatch. August 9, 1959. p. 8. Retrieved February 26, 2017.
- Mitchell, Erica. "Dr. Jane Hinton: Co-Developer of Mueller-Hinton Agar". blog.eoscu.com. Retrieved June 10, 2020.
- Bloomberg, Robert; Bird, Daniel (2015). Tufts Medical Center. Arcadia Publishing. ISBN 978-1439653708.
- Calidas, D. (October 13, 2017). "How Jane Hinton cultivated gonorrhea and saved us from antibiotic resistant bugs". Medium. Retrieved June 10, 2020.
- "Celebrating Black History Month". College of Veterinary Medicine. Michigan State University. Retrieved February 26, 2017.
- "Horizons Unlimited - The years 1952-1973". Penn Vet History. Retrieved February 26, 2017.
- Kahler, Susan C. (October 1, 2013). "Women's organization nurtured, influenced". JAVMA News. Retrieved February 26, 2017.
- "Centennial Year Affairs". Bellwether. Vol. 1, no. 12. University of Pennsylvania. Summer 1984. Retrieved February 26, 2017.
- "Deaths". Bellwether. Vol. 1, no. 56. University of Pennsylvania. Spring 2003.